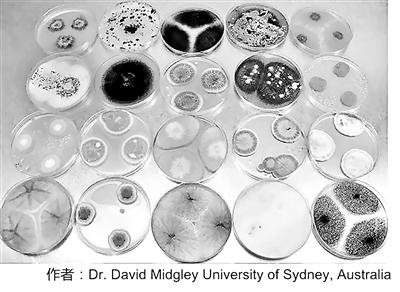
“超級真菌”肆虐全球 到底是背誰的鍋? “超級真菌”肆虐全球 到底是背誰的鍋?

“超級真菌”肆虐全球 到底是背誰的鍋?
培養皿中的真菌菌落,樣品全部來源于土壤

培養皿中的耳念珠菌
細菌的抗藥性是大家都非常熟悉的話題。致病細菌中的一些“刺兒頭”可能由于發生突變而產生對抗生素的抵抗能力。也正是基于這種“全民都知道一點名詞,但是沒有幾個人確實完全了解真相”的現狀,民眾一提到抗生素馬上就想到“濫用”和“耐藥性”,使用抗生素的時候也小心翼翼,已然成為驚弓之鳥。
然而,細菌抗藥性的話題到目前還沒被掰扯清楚,耐藥真菌又隆重登場了。2019年4月6日,美國《紐約時報》以“致命真菌,治療無解”為引子報道了一種名為“耳念珠菌”的真菌。這種真菌短短10年時間內在世界各地相繼現身,并且仍然在不斷開疆拓土。感染者約有半數在90天內死亡,最終死亡率達到60%,且目前仍無特效藥物,甚至全世界頂級的醫療機構都無能為力。
那么,這種可怕的神秘真菌是何時開始現身的?促成它們在世界各地同時出現的誘因又是什么?這次的鍋又是抗生素來背?如此高的死亡率會不會造成如中世紀黑死病一般的嚴重災難?謎團背后,除卻感嘆渺小生物亦有的頑強求生本能,人類與環境和其他生物間復雜而微妙的相互作用著實叫人細思恐極。
真菌?細菌?病毒?
在耐藥真菌的故事開始之前,我們有必要重新復習一下初中生物課上學習過的這三種微生物。
首先,從結構上來說,病毒最簡單,細菌次之,真菌比細菌還要復雜。如果把病毒比作人力平板車的話,那細菌起碼是電三輪,真菌可能就得是小汽車了。
其次,三者都可能導致人類患上疾病,并且治療時需要采取不同的方式。大部分抗生素都只針對細菌感染,病毒性疾病需要用抗病毒藥物來治療,而真菌感染也有相對應的抗真菌藥物。
例如,由于病毒結構簡單,不存在細胞壁也不自行合成蛋白質,那么以攻擊細胞壁或者阻礙蛋白質合成為抗菌手段的抗生素就無法對病毒發生作用。此外,不是所有抗生素都能夠針對各種細菌,如綠膿桿菌,它的細胞壁上開孔較小,很多抗生素無法侵入其內部,因而對其殺滅效果有限。
最后,雖然三者中都有危害人類健康的“大敵”,但也有人類生活不可或缺的盟友。多種真菌在釀造和發酵工業中不可或缺,很多細菌對人類消化和生物圈的物質循環有重要作用,病毒中也有噬菌體可以協助人類殺滅細菌或者幫助人類進行蛋白質合成等等。
肆虐全球的超級真菌:耳念珠菌
接下來,讓我們揭開耐藥真菌“耳念珠菌”的真容。耳念珠菌可引起侵襲性念珠菌病,如念珠菌菌血癥、心包炎、泌尿道感染和肺炎等。由于其多重耐藥性、致死性高、感染診斷困難的特性,它也被稱為“超級真菌”。目前,美國疾病控制與預防中心已將耳念珠菌列入“緊急威脅”名單。
2005年,日本組織科研力量對境內的真菌群落進行了一次集中普查。當時,東京都健康長壽醫療中心的醫護人員從一名70歲的日本婦女耳道中采集到了某個樣品。在之后持續多年的分析鑒定過程中,科學家們發現這件樣品無法歸類于現存的任何一種真菌。于是,日本科學家于2009年首次報道了這種被命名為“耳念珠菌”的新真菌。不料在那之后,亞洲和歐洲多國都暴發了耳念珠菌感染引發的重癥案例。
美國的第一例病例出現在2013年,當時紐約一處醫院救治了一名自訴呼吸不全癥狀的女性。這位出生于阿聯酋的61歲婦女在入院一周后檢出耳念珠菌陽性,并最終在不久后去世。不過,鑒于當時耳念珠菌還沒有目前這么大的影響力,該醫院并未將情況上報,直到2016年美國疾病預防控制中心才接到了來自院方的病例報告。
真正讓耳念珠菌開始進入大眾視野的是于2016年在英國皇家布朗普頓醫院集中暴發的感染事件。當時,該院一時間出現了72名感染病例,ICU也因此關閉了長達兩周之久。由于院方初期對情況嚴重程度的估計不足,沒有在第一時間對社會公開院內情況。
然而,據事后披露的情況顯示,早在媒體大規模介入報道之前的數個月,該院已經在內部發出過相關警報,并嘗試對疫情出現的區域進行除菌操作。作業人員用專用的氣霧劑向收治過感染該真菌患者的區域附近噴灑過氧化氫溶液,理論上這種噴劑的蒸氣會浸透到房間的每個角落。
這些房間維持過氧化氫氣霧的飽和狀態達一周之久,之后研究人員在房間中央放置一個表面皿,并觀察其底部培養基內微生物的生長情況。令人感到恐怖的是,即便如此,仍然有一個耳念珠菌群落在培養皿中現身。然而,這一事件最終被病院隱瞞了下來……
僅僅在過去五年間,耳念珠菌就在美國、西班牙、委內瑞拉、印度、巴基斯坦、南非乃至中國等地的醫院中出現,而其中尤以西班牙巴倫西亞大學醫院發生的大型感染事件最為慘烈。這所擁有992張病床的大型醫院在當時總共出現了372名感染病例,其中85人發生念珠菌菌血癥,41%的人在30天內死亡。
多地幾乎同時暴發:耐藥真菌的神秘起源
耳念珠菌從2009年被發現以來,短短十年間已經在全球多地造成多次殺傷。但真正令研究人員感到費解的是該種真菌的神秘起源及其在全球的傳播路徑。鑒于最早的病例報告于亞洲,最初科學家們推測亞洲出現的毒株引發了全球其他地區的疫情。然而,對采集自南亞、委內瑞拉、南非和日本的毒株進行遺傳信息比對后,研究人員們驚奇地發現它們屬于四個獨立的分支,彼此之間不存在親緣關系。
進一步的基因序列對比結果顯示,這四個分支大約在數千年前從同一個祖先處分離出來,并在世界各地的環境中以無害菌落的形式存在著,直到大約十年前開始同時出現耐藥性菌株。也就是說,流行于全球各地的耳念珠菌其實是在幾乎一瞬間同時出現在不同地方,幾種菌株分別在各地獨立演化,且它們之間平行傳播的可能性很小。到底是什么原因讓它們像約好了一樣一起冒出來為禍人間呢?
遺憾的是,確切的原因目前仍然不得而知。研究人員最初以耐藥細菌產生的原因作為參考,自然地認為抗真菌藥劑在臨床治療上的過量使用是造成真菌出現耐藥性的主要原因。但是,臨床上治療真菌感染的藥劑種類雖然不多,但致命性的真菌感染其實發病率很低,且抗真菌藥的應用場景和抗藥性問題暫時也不如細菌普遍。
那么,如果這鍋不讓濫用抗真菌藥來背?到底又是什么因素造成耳念珠菌的突然暴發呢?確切答案雖然還不得而知,然而,用于殺滅植物真菌的農藥很可能是背后的真實原因。
真菌與人類的相愛相殺
真菌不光可能危害動物健康,同樣會危害植物正常生長。農作物種植過程中,離不開抗真菌藥物的使用,土豆、豆類、小麥等作物都需要定期殺滅土壤中的致病真菌。與抗生素的名目繁多不同,抵抗真菌感染的藥物種類很少,并且絕大多數都是唑類化合物。而殺滅植物真菌的農藥同樣含有與唑類化合物類似的結構,這就導致在自然環境中棲息的真菌很可能在農藥的作用之下發生耐藥性突變,一旦感染人體,與農藥結構類似的抗真菌藥物也就無法發揮作用了。
其實,人類對耐藥真菌的認識達到如今的程度也經歷了一個曲折的發展歷程。大約在1997年,一種稱為煙曲霉菌的常見真菌開始顯現耐藥性,由耐藥煙曲霉菌引發的肺炎死亡率高達60%。起初,醫學工作者自然地認為治療過程中抗真菌藥劑的使用是造成真菌菌株發生耐藥性變異的原因,治療中對耐藥菌株占總菌株比例的監測事實也似乎證實了這一猜測。
然而,研究過程中卻發現不少從未經過唑類化合物治療的患者體內也發現了耐藥性菌株,這說明耐藥性菌株在真菌感染患者之初就已經存在了。據此,研究人員開始懷疑環境中本來就已經有耐藥菌株的存在,而隨后的實驗結果佐證了這一猜測。
研究人員在醫院周圍的花壇、草叢以及空調系統中都發現了耐藥菌株的存在,土壤樣品中耐藥菌株占比高達12%。另外,與醫用唑類藥物結構類似的抗真菌用脫甲基抑制劑(DMI)類農藥在世界農藥市場中所占份額高達三分之一,而耐藥菌株對DMI類農藥也表現出了相應的抵抗能力。
雖然這些觀測事實還不足以斷定農藥應用是真菌耐藥性產生的直接原因,但可以斷定的是,自然界中已經存在大量的耐藥性真菌,并且它們的威力與耳念珠菌不相上下。真菌感染原本以侵襲免疫力低下人群為主,當藥物能夠正常發揮作用時,感染會很快得到有效抑制。一旦抗藥性真菌出現,“人類武器庫”中原本就有限的選擇就會捉襟見肘,從而造成易感人群的較高死亡率。
新型抗真菌藥將從農藥中找靈感
未來,除了進一步探究真菌耐藥性、抗菌藥物和農藥間的關聯性,開發抑菌機理迥異的新型抗真菌藥同樣迫在眉睫。然而,由于真菌和人類細胞同屬真核細胞,兩者間存在諸多聯系,對真菌細胞有殺滅作用的藥物也往往會傷害人體正常細胞,所以人類目前僅能從有限的幾個人類與真菌細胞的不同之處出發,來設計抗真菌藥物。不幸的是,這些藥物中的大部分已經不能有效殺滅耐藥菌株了。
不過,有不少學者卻提出人類其實可以從抗真菌農藥中尋找靈感。這是因為除去DMI類藥劑,還有若干種農藥可以在有效殺滅真菌的情況下保持較低的人體毒性。而這些農藥中的相當一部分至今仍處于殺菌機理并未完全解明的狀態。從這些行之有效的抗真菌農藥中尋找藥物設計靈感的思路不失為合理的選擇。
事實上,抗藥性在抗生素、抗病毒藥物、抗真菌藥物、抗寄生蟲藥物乃至抗癌藥物等各種化學療法領域都是長久以來存在的問題,是無法回避的宿命。我們要明白人類與微生物的博弈過程將是一場長期而且不斷升級的戰斗。在這一過程中,我們既要合理使用抗菌藥劑,又要避免因藥物不適當應用造成的抗藥性。同時,我們還需要將人類與致病微生物所在的整個生態系統都納入到研究和討論的范圍之內。
文/科學大院公眾號 張昊





